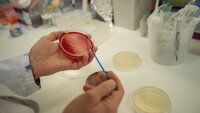
Bildet viser hender og en petriskål.

Innlegg av Nina Hernæs som journalist:
Svensk sykepleier døde etter covid-19 – politiet henlegger
Covid-19 ikke var hovedårsaken til at den 39 år gamle sykepleieren døde, ifølge obduksjonsrapporten.
Jul også på teststasjonen
21 DAGER IGJEN TIL JUL: Rampenissen har ankommet Aker BPs teststasjon på Sola.
Lege i Sverige sparket etter å ha gått på jobb med covid-19-symptomer
Legen reagerer sterkt på oppsigelsen.
«Trenger noe å smile av»
22 DAGER IGJEN TIL JUL: Sykepleier og komiker Lars Berrum har fått i oppdrag å lage Diakonhjemmets julekalender i år.
«Pussbekken-rudolfen får oss til å smile»
23 DAGER IGJEN TIL JUL: Intensivsykepleierne jobber på hovedintensiv på St. Olavs hospital i Trondheim.
Daniel gleder seg til å jobbe i julen
24 DAGER IGJEN TIL JUL: Daniel Hunstad er sykepleier på barnemedisinsk avdeling på Ullevål sykehus i Oslo. På hans avdeling er det pasienter i alderen null til 18 år, og de har tilstander innen blant annet gastro, nevro, lunge- og endokrinologi.
Gjør som nyrelabben: Vis frem hvordan dere pynter til jul!
Det går tidvis hardt for seg når det settes frem sjokolade på nyrelabben, men kalenderen håper de får være i fred helt til julaften.
Korona i det åpne rusmiljøet i Oslo: Vekker bekymring
– Det siste disse menneskene trenger, er flere virusinfeksjoner som angriper helsen deres, sier Aino Lundberg i 24sju.
Oppdaget en helt ny stafylokokk
Kan være første gang en ny stafylokokkart er oppdaget i Norge.
Helsepersonell i Italia: I vår ble de klappet for, nå trakasseres de
«Vi har gått fra å bli feiret som helter til å være smittebærere», sier sjefen på en intensivavdeling i Milano.